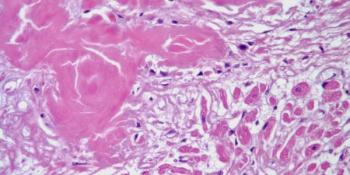
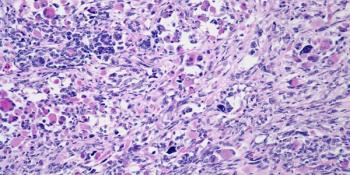

A 47-year-old man presents with shortness of breath and is found to have an anterior mediastinal mass. A biopsy is performed. What is your diagnosis?

Your AI-Trained Oncology Knowledge Connection!


A 47-year-old man presents with shortness of breath and is found to have an anterior mediastinal mass. A biopsy is performed. What is your diagnosis?

A 57-year-old man presents with swelling of the scrotum. What is your diagnosis?

A 43-year-old man presents with a right thigh mass, and a biopsy is performed. What is your diagnosis?

A 47-year-old man presents with nausea and vomiting. A gastric biopsy is obtained. What is your diagnosis?
A 73-year-old man presents with congestive heart failure and a cardiac biopsy is performed. What is your diagnosis?

A 12-year-old boy is found to have an abdominal mass and a biopsy is performed. What is your diagnosis?

A 50-year-old man undergoes CT examination for workup of hematuria and abdominal pain. Noncontrast and postcontrast images from the CT are shown. What is your diagnosis?

A vaginal mass is discovered in a 29-year-old woman. A biopsy is performed. What is your diagnosis?

A 47-year-old man presents with a lip mass. A biopsy is performed. What is your diagnosis?

A 12-year-old boy presents with a mass on the right side of the neck. What is your diagnosis?
A 27-year-old man presents with a mass in the right calf. A biopsy is performed. What is your diagnosis?
.JPG?w=350&fit=crop&auto=format)
A 63-year-old man presents with cough and shortness of breath. After further evaluation, a mass in the right upper lobe is found and a biopsy is performed. What is your diagnosis?

A 20-year-old young man presents with hypertension and a left kidney mass. After further evaluation, a biopsy is performed. What is your diagnosis?

A 44-year-old woman is found to have a large mass in the anterior mediastinum. What is your diagnosis?

A 54-year-old man presents with diffuse peritoneal thickening. What is your diagnosis?

A 28-year-old woman with a history of nephrolithiasis has an abdomen CT scan to investigate an abnormality in the liver. What is your diagnosis?

A 75-year-old male patient develops painful erythema around his nails 10 weeks after starting cancer treatment. Which medication is most likely responsible?

A 47-year-old man presents with pain in the right flank. A kidney mass is found on imaging.
.JPG?w=350&fit=crop&auto=format)
A 52-year-old woman was found to have a small tumor in the uterus. After further evaluation, a biopsy was performed. What is your diagnosis?

A 43-year-old woman presents with enlargement of the thyroid gland. What is your diagnosis?